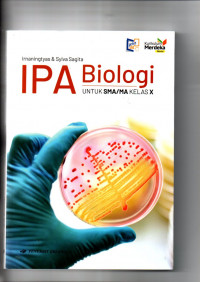
Biologi Kelas 10

BUKU PAKET
Biologi Kelas 10
Tidak Tersedia Deskripsi
Ketersediaan
| BIO.10 ERL.1 | 570 Irn B TP 2025 | My Library (Biologi) | Tersedia |
| BIO.10 ERL.2 | 570 Irn B TP 2025 | My Library (Biologi) | Tersedia |
| BIO.10 ERL.3 | 570 Irn B TP 2025 | My Library (Biologi) | Tersedia |
| BIO.10 ERL.4 | 570 Irn B TP 2025 | My Library (Biologi) | Tersedia |
| BIO.10 ERL.5 | 570 Irn B TP 2025 | My Library (Biologi) | Tersedia |
| BIO.10 ERL.6 | 570 Irn B TP 2025 | My Library (Biologi) | Tersedia |
| BIO.10 ERL.7 | 570 Irn B TP 2025 | My Library (Biologi) | Tersedia |
| BIO.10 ERL.8 | 570 Irn B TP 2025 | My Library (Biologi) | Tersedia |
| BIO.10 ERL.9 | 570 Irn B TP 2025 | My Library (Biologi) | Tersedia |
| BIO.10 ERL.10 | 570 Irn B TP 2025 | My Library (Biologi) | Tersedia |
| BIO.10 ERL.11 | 570 Irn B TP 2025 | My Library (Biologi) | Tersedia |
| BIO.10 ERL.12 | 570 Irn B TP 2025 | My Library (Biologi) | Tersedia |
| BIO.10 ERL.13 | 570 Irn B TP 2025 | My Library (Biologi) | Tersedia |
| BIO.10 ERL.14 | 570 Irn B TP 2025 | My Library (Biologi) | Tersedia |
| BIO.10 ERL.15 | 570 Irn B TP 2025 | My Library (Biologi) | Tersedia |
| BIO.10 ERL.16 | 570 Irn B TP 2025 | My Library (Biologi) | Tersedia |
| BIO.10 ERL.17 | 570 Irn B TP 2025 | My Library (Biologi) | Tersedia |
| BIO.10 ERL.18 | 570 Irn B TP 2025 | My Library (Biologi) | Tersedia |
| BIO.10 ERL.19 | 570 Irn B TP 2025 | My Library (Biologi) | Tersedia |
| BIO.10 ERL.20 | 570 Irn B TP 2025 | My Library (Biologi) | Tersedia |
| BIO.10 ERL.21 | 570 Irn B TP 2025 | My Library (Biologi) | Tersedia |
| BIO.10 ERL.22 | 570 Irn B TP 2025 | My Library (Biologi) | Tersedia |
| BIO.10 ERL.23 | 570 Irn B TP 2025 | My Library (Biologi) | Tersedia |
| BIO.10 ERL.24 | 570 Irn B TP 2025 | My Library (Biologi) | Tersedia |
| BIO.10 ERL.25 | 570 Irn B TP 2025 | My Library (Biologi) | Tersedia |
| BIO.10 ERL.26 | 570 Irn B TP 2025 | My Library (Biologi) | Tersedia |
| BIO.10 ERL.27 | 570 Irn B TP 2025 | My Library (Biologi) | Tersedia |
| BIO.10 ERL.28 | 570 Irn B TP 2025 | My Library (Biologi) | Tersedia |
| BIO.10 ERL.29 | 570 Irn B TP 2025 | My Library (Biologi) | Tersedia |
| BIO.10 ERL.30 | 570 Irn B TP 2025 | My Library (Biologi) | Tersedia |
| BIO.10 ERL.31 | 570 Irn B TP 2025 | My Library (Biologi) | Tersedia |
| BIO.10 ERL.32 | 570 Irn B TP 2025 | My Library (Biologi) | Tersedia |
| BIO.10 ERL.33 | 570 Irn B TP 2025 | My Library (Biologi) | Tersedia |
| BIO.10 ERL.34 | 570 Irn B TP 2025 | My Library (Biologi) | Tersedia |
| BIO.10 ERL.35 | 570 Irn B TP 2025 | My Library (Biologi) | Tersedia |
| BIO.10 ERL.36 | 570 Irn B TP 2025 | My Library (Biologi) | Tersedia |
| BIO.10 ERL.37 | 570 Irn B TP 2025 | My Library (Biologi) | Tersedia |
| BIO.10 ERL.38 | 570 Irn B TP 2025 | My Library (Biologi) | Tersedia |
| BIO.10 ERL.39 | 570 Irn B TP 2025 | My Library (Biologi) | Tersedia |
| BIO.10 ERL.40 | 570 Irn B TP 2025 | My Library (Biologi) | Tersedia |
| BIO.10 ERL.41 | 570 Irn B TP 2025 | My Library (Biologi) | Tersedia |
| BIO.10 ERL.42 | 570 Irn B TP 2025 | My Library (Biologi) | Tersedia |
| BIO.10 ERL.43 | 570 Irn B TP 2025 | My Library (Biologi) | Tersedia |
| BIO.10 ERL.44 | 570 Irn B TP 2025 | My Library (Biologi) | Tersedia |
| BIO.10 ERL.45 | 570 Irn B TP 2025 | My Library (Biologi) | Tersedia |
| BIO.10 ERL.46 | 570 Irn B TP 2025 | My Library (Biologi) | Tersedia |
| BIO.10 ERL.47 | 570 Irn B TP 2025 | My Library (Biologi) | Tersedia |
| BIO.10 ERL.48 | 570 Irn B TP 2025 | My Library (Biologi) | Tersedia |
| BIO.10 ERL.49 | 570 Irn B TP 2025 | My Library (Biologi) | Tersedia |
| BIO.10 ERL.50 | 570 Irn B TP 2025 | My Library (Biologi) | Tersedia |
Informasi Detail
- Judul Seri
-
-
- No. Panggil
-
570 Irn B TP 2025
- Penerbit
- Jakarta : Erlangga., 2025
- Deskripsi Fisik
-
-
- Bahasa
-
Indonesia
- ISBN/ISSN
-
978-623-180-787-8
- Klasifikasi
-
570
- Tipe Isi
-
-
- Tipe Media
-
-
- Tipe Pembawa
-
-
- Edisi
-
-
- Subjek
- Info Detail Spesifik
-
-
- Pernyataan Tanggungjawab
-
Irnaningtyas dan Sylva Sagita
Versi lain/terkait
Tidak tersedia versi lain
Lampiran Berkas
Komentar
Anda harus login sebelum memberikan komentar
 Karya Umum
Karya Umum  Filsafat
Filsafat  Agama
Agama  Ilmu-ilmu Sosial
Ilmu-ilmu Sosial  Bahasa
Bahasa  Ilmu-ilmu Murni
Ilmu-ilmu Murni  Ilmu-ilmu Terapan
Ilmu-ilmu Terapan  Kesenian, Hiburan, dan Olahraga
Kesenian, Hiburan, dan Olahraga  Kesusastraan
Kesusastraan  Geografi dan Sejarah
Geografi dan Sejarah